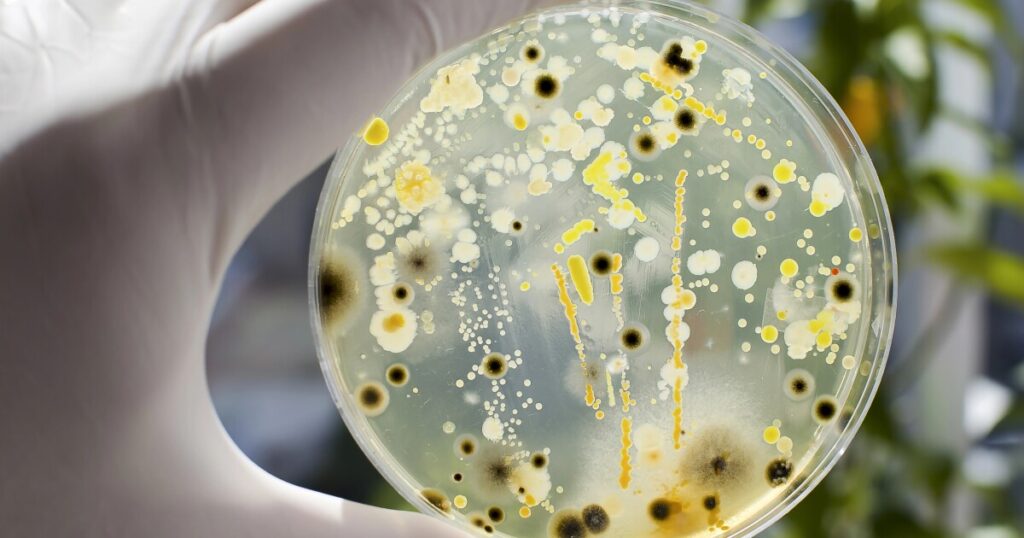

For the primary time, scientists have recognized 27 micro organism and fungi dwelling in our mouths which might be implicated within the growth of pancreatic most cancers. Collectively, housing all the dangerous microbes will increase one’s danger of the lethal illness by 250% – or 3.5 occasions increased – in comparison with the final inhabitants.
Researchers from NYU Langone Well being and its Perlmutter Most cancers Heart sampled the saliva of 122,000 wholesome US women and men, who took half within the American Most cancers Society Most cancers Prevention Research II and the Prostate, Lung, Colorectal, and Ovarian Most cancers Screening Trial. Samples have been collected at baseline, and individuals have been adopted for a median of 9 years, with any data of tumors added to the information.
From this massive dataset, the researchers recognized 445 individuals who’d finally been identified with pancreatic most cancers. Their microbial DNA was analyzed and in contrast with one other 445 randomly chosen cancer-free individuals within the trials. They then factored in variables resembling age, race and smoking habits.
What they discovered was that 24 species of micro organism and fungi every both raised or lowered the danger of pancreatic most cancers. This was along with three sorts of micro organism that had already been implicated within the growth of periodontal illness, the an infection that erodes gum tissue and bone across the enamel. Individuals with the particular combo of problematic microbes had a 350% increased danger of growing pancreatic most cancers in contrast with the final inhabitants.
And this examine is the primary to determine a group of particular microbes that contribute to the most cancers danger, and that one fungi – a kind of yeast within the genus Candida that lives on the pores and skin and all through the physique – seems to play a particular position. These oral Candida species have been additionally current within the tissue of sufferers’ pancreatic tumors.
“Our findings present new perception into the connection between the oral microbiome and pancreatic most cancers,” stated examine lead writer Yixuan Meng, a postdoctoral fellow within the Division of Inhabitants Well being on the NYU Grossman Faculty of Drugs.
Pancreatic most cancers will not be the most typical, nevertheless it’s one of many deadliest. The American Cancer Society discovered that simply 8% of individuals identified with the illness will dwell greater than 5 years – this makes it the bottom five-year survival fee of the greater than 20 sorts of widespread cancers.
Scientists have beforehand recognized a hyperlink between the oral microbiome and pancreatic cancer, and theorized that sure micro organism might hitch a experience on swallowed saliva and travels to the organ.
What this analysis has uncovered is a robust new software in superior most cancers diagnostics, enabling clinicians to intervene earlier than tumor growth, with remedy centered on correcting the variety and abundance of species within the microbiome. Proper now, there are only a few efficient screening strategies that may assess danger of future illness.
“By profiling bacterial and fungal populations within the mouth, oncologists could possibly flag these most in want of pancreatic most cancers screening,” stated examine co-senior writer Jiyoung Ahn, a professor on the NYU Grossman Faculty of Drugs.
Whereas the analysis solely establishes a hyperlink between these 27 microbes and pancreatic most cancers, it is essentially the most complete understanding we now have as to how our mouths contribute to illness elsewhere within the physique. Extra analysis is required to unravel what mechanisms could also be driving this danger.
“It’s clearer than ever that brushing and flossing your enamel might not solely assist forestall periodontal illness however may defend towards most cancers,” stated examine co-senior writer Richard Hayes, a professor within the Division of Inhabitants Well being.
In 2024, the identical crew of researchers made one other discovery, linking sure oral microbiome species to an elevated danger of growing head and neck squamous cell carcinoma – which originates within the cells lining the moist surfaces of the mouth, nostril and throat. Subsequent, they’re going to be taking a look at whether or not oral viruses worsen most cancers odds, and if sure microbes contribute to the survival probabilities of these with pancreatic most cancers.
The findings at the moment are a part of a rising physique of proof linking oral hygiene to poor well being outcomes throughout the physique, together with Alzheimer’s disease and mental health conditions together with depression.
The examine was revealed within the journal JAMA Oncology.
Supply: NYU Langone Health